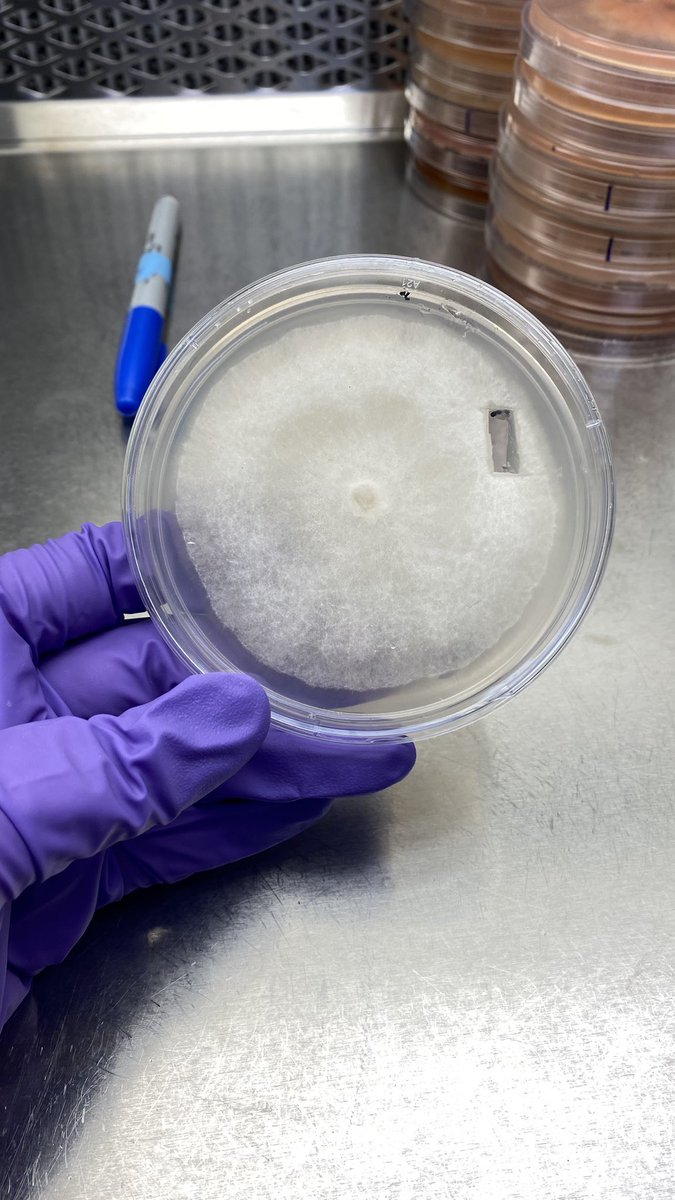

Kennedy Ellis
@kennedyanneturf
Michigan State @TurfState @TurfMgmtWomen @APS_Turfgrass. Aspiring turf doc. Adopted by: @PSUTurf and @CarolinasGCSA. Blogger. Sweet Tea. (she/her)🏳️🌈🏳️⚧️
ID: 1320460313867784198
https://www.kennedyturfcorner.com/ 25-10-2020 20:22:35
2,2K Tweet
2,2K Followers
2,2K Following



My first disease discovery… “trash patch” APS Turfgrass Pathology Committee I’ll work on my submission for the next edition of the Compendium of Turfgrass Diseases. 😂😂😂







My favorite spot of the GCSAA Conference and Trade Show Store ❤️❤️ “I have that one and that one, but oooo I want that one..” 😂










I survived The Buffalo River and the views were worth it!!!! PLUS I spent the day with my U of A turfies!!!! 10/10 would recommend Mike Richardson for all your river tours!!!